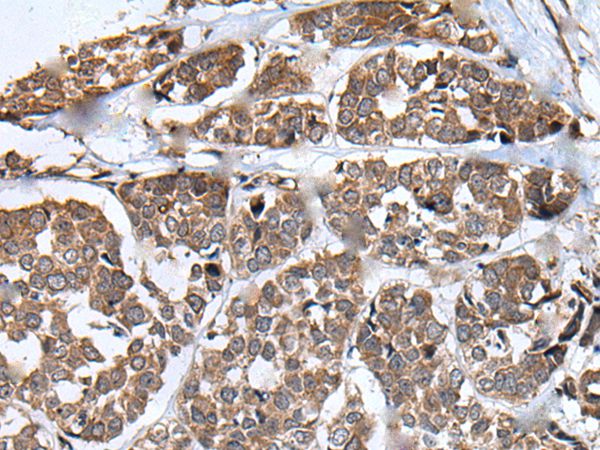

Rabbit anti-NSD2 Antibody, Affinity Purified
A303-093A
ApplicationsWestern Blot
Product group Antibodies
ReactivityHuman
TargetNSD2
Product A303-093A is not available
Product not available
There may be an alternative product available, please contact our technical support team.
Overview
- SupplierBethyl Laboratories
- Product NameRabbit anti-NSD2 Antibody, Affinity Purified
- Delivery Days Customer9
- ApplicationsWestern Blot
- CertificationResearch Use Only
- ClonalityPolyclonal
- Concentration200 ug/ml
- ConjugateUnconjugated
- Estimated Purity...
- Gene ID7468
- Target nameNSD2
- Target descriptionnuclear receptor binding SET domain protein 2
- Target synonymsKMT3F, KMT3G, MMSET, RAUST, REIIBP, TRX5, WHS, WHSC1, histone-lysine N-methyltransferase NSD2, IL5 promoter REII region-binding protein, Wolf-Hirschhorn syndrome candidate 1, multiple myeloma SET domain containing protein type III, nuclear SET domain-containing protein 2, probable histone-lysine N-methyltransferase NSD2, trithorax/ash1-related protein 5
- HostRabbit
- IsotypeIgG
- Protein IDO96028
- Protein NameHistone-lysine N-methyltransferase NSD2
- ReactivityHuman
- Storage Instruction2°C to 8°C
- UNSPSC12352203